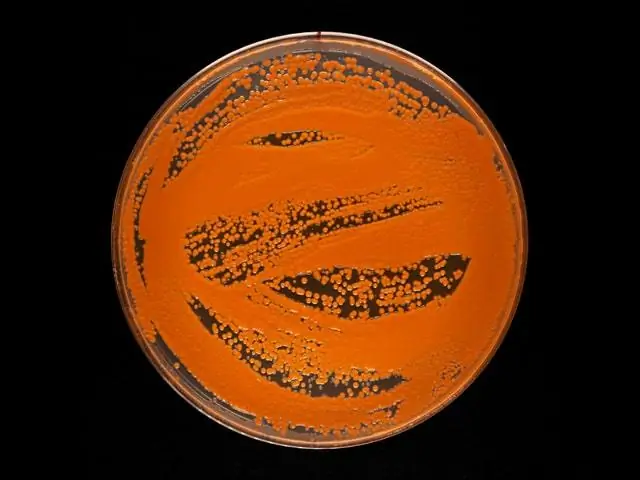
Грибы имеют огромный потенциал для создания новых антибиотиков

Грибы являются потенциальной золотой жилой для производства фармацевтических препаратов. Это показали исследователи из Технологического университета Чалмерса, которые разработали метод поиска новых антибиотиков из природных ресурсов. Результаты, которые могут оказаться очень полезными в борьбе с устойчивостью к антибиотикам, были недавно опубликованы в журнале Nature Microbiology.
Антибиотики спасли миллионы жизней с момента их открытия в 1940-х годах. Но недавно нам пришлось выучить новый термин: устойчивость к антибиотикам. Все больше и больше бактерий вырабатывают собственную защиту от антибиотиков, тем самым становясь устойчивыми к лечению. Это приведет к тому, что простые инфекции снова станут смертельными. Нам срочно нужны новые антибиотики.
Первым антибиотиком, начавшим массовое производство, был пенициллин, полученный из грибов рода Penicillium. В поисках новых антибиотиков исследователи из Чалмерса секвенировали геномы девяти различных видов Penicillium. И выводы поразительные:
«Мы обнаружили, что грибы обладают огромным, ранее неиспользованным потенциалом для производства новых антибиотиков и других биоактивных соединений, таких как лекарства от рака», - говорит Йенс Кристиан Нильсен, аспирант кафедры биологии и биологии. Инженерия.
Он работает в исследовательской группе под руководством другого исследователя Чалмерса с почти таким же именем: профессора Йенса Нильсена.
В исследовании, недавно опубликованном в журнале Nature Microbiology, исследовательская группа просканировала геномы 24 различных видов грибов, чтобы найти гены, ответственные за производство различных биологически активных соединений, таких как антибиотики. Было обнаружено более 1000 путей, демонстрирующих огромный потенциал грибов для производства большого разнообразия природных и биоактивных химических веществ, которые можно использовать в качестве фармацевтических препаратов.
Примерно в 90 случаях исследователи смогли предсказать химические продукты путей. В качестве доказательства этого они следили за производством антибиотика янутона и выявили новые грибы, способные производить соединение, а также то, что некоторые виды могут производить новую версию лекарства.
В целом, исследование показывает огромный потенциал грибов не только в производстве новых антибиотиков, но и в обеспечении более эффективного производства существующих и, возможно, более эффективных версий существующих.
«Важно найти новые антибиотики, чтобы дать врачам широкую палитру антибиотиков, как существующих, так и новых, для использования в лечении. Это затруднит развитие резистентности бактерий», - объясняет Йенс. Кристиан Нильсен.
Предыдущие усилия по поиску новых антибиотиков в основном были сосредоточены на бактериях. Грибы было трудно изучать - мы очень мало знаем о том, на что они способны, - но мы знаем, что они естественным образом вырабатывают биологически активные вещества, как способ защитить себя и выжить в конкурентной среде. Поэтому было логично применить наши исследовательские инструменты к грибам».
Исследователи теперь могут идти разными путями. Одним из способов продвижения вперед может быть дальнейшее изучение производства нового соединения янутона. Исследователи из Чалмерса также составили карту, которая позволяет сравнивать сотни генов при непрерывной оценке биологически активных продуктов с сильнодействующими лекарствами в поле зрения.
Сколько времени потребуется, чтобы вывести на рынок новые антибиотики, сказать невозможно.
Правительства должны действовать. Фармацевтическая промышленность не хочет тратить деньги на новые антибиотики, это невыгодно. Вот почему наши правительства должны вмешаться и, например, поддержать клинические исследования. Их поддержка облегчит выход на рынок, особенно для небольших компаний. Это может стимулировать производство», - говорит Йенс Кристиан Нильсен.